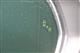

実車確認可能
レクサスNX300 Fスポーツ
実車確認可能
■修復歴有■ 修復歴がございますが、走行に支障の無い状態のお車です


写真でクルマをチェック
-
支払総額
323万円
-
車両価格
309万円
-
諸費用
14万円
※価格は展示店にて6月登録の場合 ※消費税10%込み
福岡トヨタ/長崎トヨタ
福岡トヨタ特選展示場北九州
近隣都道府県への販売に限らせていただきます。
車両詳細
| 年式 | 2019年(R1年) | ドア枚数 | 5枚 |
|---|---|---|---|
| 車検 | 車検整備付 | 全長 | 464cm |
| エンジン | ガソリン | 全幅 | 184cm |
| 排気量 | 2,000cc | 全高 | 164cm |
| 駆動方式 | FF | 乗車定員 | 5名 |
| 走行距離 | 60,000km | 使用歴 | 自家用 |
| ミッション | フロアAT6 | 法定整備 | 定期点検整備付 |
| ボディカラー | ホワイトノーヴァガラスフレーク | 修復歴 | あり(修復部位の詳細はお尋ね下さい。) |
| ハンドル | 右 | ||
| 保証内容※1 | 保証付:ロングラン保証1年<走行距離無制限> |
|---|---|
| リサイクル料金 | 預託済(支払総額に含む)/廃車時追加料金必要装備付の場合あり |
1:記載内容とは別に、距離・年式に応じて新車保証が付いている場合があります。詳細は販売店にお尋ねください。
装備・オプション
| 基本装備 | |||
|---|---|---|---|
| フロントエアコン | オート | リヤエアコン | - |
| パワステ | ○ | パワーウィンドウ | ○ |
| アイドリングストップ | - | ||
| 安全・視界 | |||
|---|---|---|---|
| 衝突被害軽減ブレーキ | Toyota Safety Sense・ Lexus Safety Systemの プリクラッシュセーフティ (対車両・歩行者) | ペダル踏み間違い 急発進抑制装置 | インテリジェントクリアランスソナー・ スマートアシスト |
| 車線逸脱警報 | ○ | 先進ライト | ○ |
| エアバッグ | デュアル+サイド+リアエアバッグ | ABS | ○ |
| 横滑防止装置 | ○ | ヘッドランプ (HID/LED) | LED |
| バックモニター | ○ | ブラインドスポットモニター (後側方検知) | ○ |
| パノラミックビューモニター (全周囲カメラ) | - | ドライブレコーダー | - |
| ナビ・オーディオ | |||
|---|---|---|---|
| カーナビ/DA | メモリーナビ(IN) またはナビ付きDA | TV | 地デジ(フルセグ) |
| DVD再生装置 | ○ | CD再生装置 | ○ |
| メディアプレイヤー 接続 | ○ | 後席モニター | - |
| 電源コンセント | AC100V/100W | ||
| 外装 | |||
|---|---|---|---|
| ローダウン | - | エアロパーツ | - |
| シート素材 | 本革 | パワーシート | ○ |
| 3列シート | - | アルミホイール | 純正アルミ |
| サンルーフ | ○ | 1⇔2列目 ウォークスルー | - |
| フルフラット | - | ベンチシート | - |
| 操作性 | |||
|---|---|---|---|
| キーレス | スマートキ- | イモビライザー | ○ |
| クルーズコントロール | ○ | 電動スライドドア | - |
| リモコンスターター | - | ||
| その他 | |||
|---|---|---|---|
| ETC | ○ ※セットアップ費用は別途申し受けます |
点検記録簿 | ○ |
| 寒冷地仕様 | - | ウェルキャブ | - |
| ワンオーナー | - | 試乗車 | - |
店舗管理ナンバー【081016012548】車台番号(下3桁)【527】
- 支払総額には、車両価格の他、保険料、税金、登録などに伴う費用など、購入の際に必要な全ての費用が含まれております。
- 「定期点検整備なし(要整備箇所あり)」の場合、整備箇所につきましては、販売店へお問合せください。
- 「修復歴あり」の場合、修復部位の詳細につきましては、販売店へお問合せください。
- 「車検整備付」の場合、車検の有効期限が切れているため、納車時までに、乗用車は24ヵ月、
商用車などは12ヵ月定期点検整備を実施し、車検を取得して納車します(費用は支払総額に含む)。 - グレードによって予防安全装置の設定が異なる場合があります。
- グレードや予防安全装置の設定によって同じ車種でも安全運転サポート車の区分が異なる場合があります。
- 予防安全装置の各機能の作動には、速度や対象物等の条件があります。また、道路状況、車両状態、天候等により作動しない場合があります。
詳しくは、販売店スタッフにおたずねください。 - 予防安全装置はドライバーの安全運転を支援するためのものです。機能を過信せず、安全運転を心掛けてください。
- 詳しい情報は、販売店へ直接お問合せください。
予防安全機能詳細衝突被害軽減ブレーキ

運転中のさまざまな状況で、
ぶつからないようにサポート。
品質情報
- このクルマの評価点
-
R

- 自動車公正取引協議会 監修
- 表示項目・方法・運用体制等について、自動車公正取引協議会の定める基準を満たした「トヨタU-Car品質評価制度」に基づき作成しております。
- 日本自動車査定協会 定期監査
- 日本自動車査定協会による監査も定期的に実施しています。
| 総合評価 | R | 修復歴がありますが、走行には支障ありません。 |  |
|---|---|---|---|
| 外装評価 | C | 標準的に使用されていて、キズやへこみなどが若干あります。 |  |
| 内装評価 | D | 気になる使用感やいたみが複数あります。 |  |
車両外装状態
記号の部分を押すと、状態のイメージ写真が表示されます。
- 車両外装状態の表記記号について
-
キズの種類は英字、キズの状態は数字で表示され、これらの組み合わせが、展開図中に表示されます。
タイヤの横の数字は、残り溝を示しています。
 は応急タイヤの装着を示しています。
は応急タイヤの装着を示しています。

- 修復歴
- あり(修復部位の詳細はお尋ね下さい。)
- 特記事項
-
- ミラーA
- モールA
- ▼センターピラーU
- タイヤひび割れ
- 内装特記事項
-
- コンソール傷あり
- シフトノブすれあり
- 天張汚れあり
- ドア内張キズあり
- ハンドルすれあり
- ピラー内張キズあり
- シートしわあり
- 室内臭いあり
- 注1)本ページに掲載された評価は、車両検査実施時の車両状態を示したものです。
検査には厳正を期しておりますが、保証したものではございませんのでその旨ご了承ください。
詳細及び現状の車両状態につきましては、店舗スタッフまでお尋ねください。 - 注2)上記と同様の評価点・状態表を「車両検査証明書」として店舗の展示車両に搭載しております。
10cm未満の線キズ(拳大程度まで)

10cm未満の線キズ(拳大程度まで)

キズのあるもの

補修跡のある状態(光や見る角度によっては板金跡が確認できる)

10cm未満の線キズ(拳大程度まで)

交換済みのもの

10cm未満の線キズ(拳大程度まで)

10cm未満の線キズ(拳大程度まで)

交換済みのもの

点キズ(飛び石によるキズ)のあるもの

補修跡のある状態(光や見る角度によっては板金跡が確認できる)

10cm未満の線キズ(拳大程度まで)

補修跡のある状態(光や見る角度によっては板金跡が確認できる)

キズのあるもの

販売店情報

- 福岡トヨタ/長崎トヨタ福岡トヨタ特選展示場北九州
-
レクサス中古車を集結させたお店です。きっとあなたの特別な1台が見つかります!
-
住所 〒802-0073 北九州市小倉北区貴船町2-2 TEL 093-967-0399 093-967-0399 営業時間 平日 :09:30~19:00
土曜日:10:00~19:00
日曜日:10:00~19:00
祝日 :10:00~19:00Web このお店のウェブページを見る
おすすめ支払プラン
らくらく支払プラン
頭金0円!ボーナス払い0円!
月々60,800円
- ・支払回数60回(5年)、実質年率6.8%、割賦元金3,090,000円、初回支払額66,459円、割賦支払総額3,653,659円
- ・諸費用(14万円)を登録時までに現金で別途申し受けます。
- ・このお支払プランは一例です。詳しくは販売店スタッフまで。
この物件は以下の店舗でもご商談いただけます対応できない場合や輸送料が別途必要となる場合があります。詳しくは販売店までおたずねください。
福岡トヨタ/長崎トヨタのU-Car(中古車)店舗
![]()





![]()
フルスクリーンでの再生は
横画面でご覧ください。

閉じる
![]()
レクサス NX300 Fスポーツ
![]()